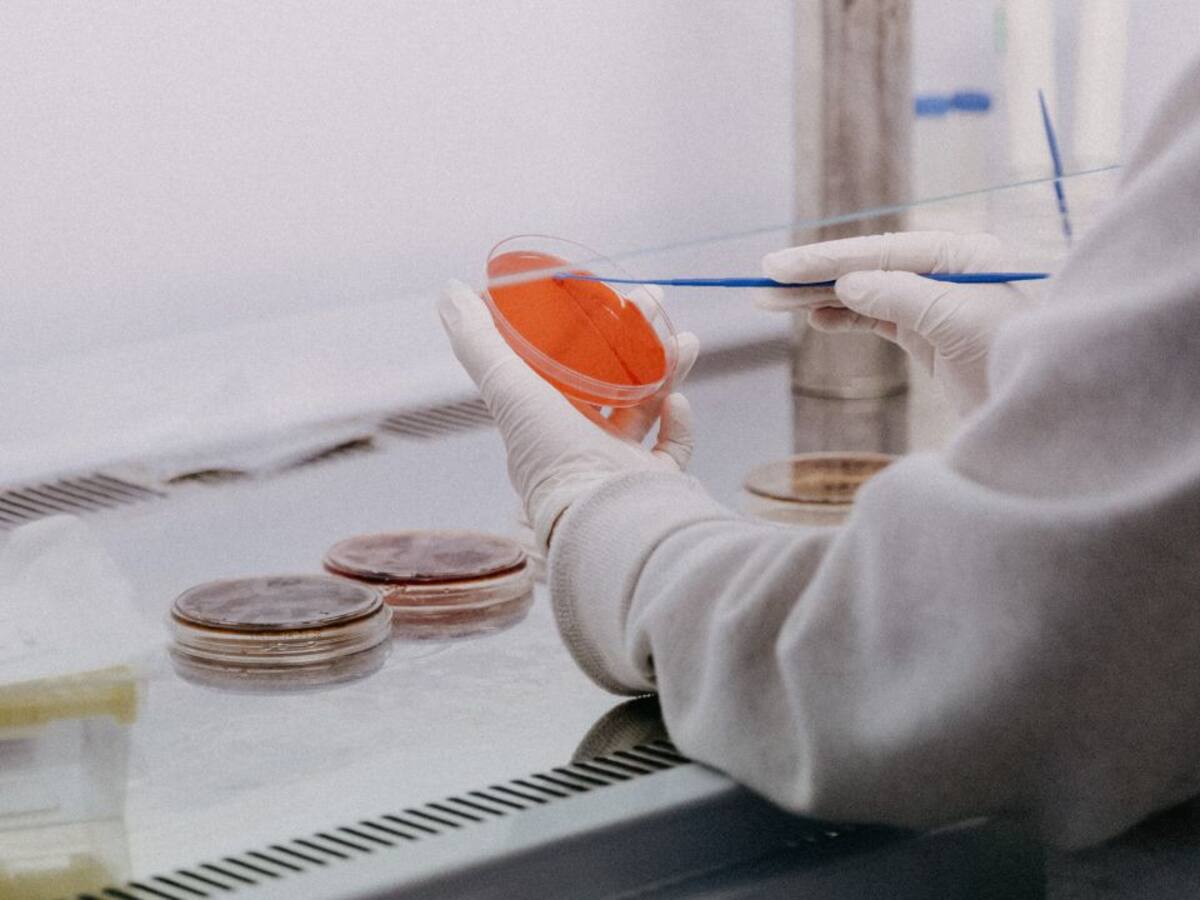

Escuchar
00:06
Daniel López Acuña: "Tomar medidas como el confinamiento evitaría un número de fallecimientos importante"
El epidemiólogo ha apuntado que si hay dosis suficientes y una capacidad del sistema sanitario se podría llegar a la inmunidad de grupo en junio o julio
22/01/2021 - 23:24
Josu Alonso
Asturias